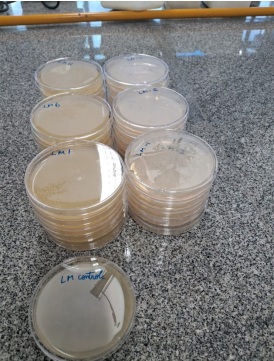

Um estudo inédito da Universidade Federal do Vale do São Francisco (UNIVASF) investiga a qualidade microbiológica da carne caprina e ovina vendida na região. A pesquisa é conduzida por doutorandas do Programa de Pós-Graduação em Ciências Veterinárias no Semiárido, com apoio do Laboratório de Microbiologia da universidade.
A doutoranda Carla Maria do Carmo Resende explicou que amostras foram coletadas em quatro pontos: restaurantes, abatedouro, feira livre e supermercados. Os dados ainda estão sendo tabulados, mas os resultados preliminares apontam a feira como o local com maior contaminação, seguida pelos supermercados.
Foram analisados produtos como carne in natura, buchada, linguiça, hambúrguer e “cafata”, com foco em cinco bactérias: Salmonella, Escherichia coli, Staphylococcus, mesófilos e psicotróficos. “Na feira foi o único local onde encontramos Salmonella, que está associada a surtos de doenças transmitidas por alimentos”, destacou Carla.
O professor Gomes Martins ressalta que o estudo vai além das exigências da legislação. “Adotamos critérios ampliados para uma avaliação mais profunda. A presença de Salmonella é preocupante, como no caso de Jacobina (BA), onde um surto atingiu 400 professores, com uma morte confirmada.”
A pesquisa também apontou contaminação por Escherichia coli, indicando presença de fezes e falhas na higiene durante o manuseio. “Muitas vezes, o problema está nas facas, bancadas e mãos de manipuladores mal higienizados”, alertou Gomes.
O estudo visa mapear a qualidade sanitária da carne nos pontos de venda e fornecer dados aos órgãos fiscalizadores. Também está prevista a capacitação de manipuladores para reduzir os riscos de contaminação.
Carla orienta os consumidores sobre o risco de contaminação cruzada em casa: “Mesmo cozida, a carne ainda pode conter bactérias. Usar os mesmos utensílios para carne crua e salada, por exemplo, pode contaminar os alimentos.”

A pesquisa será concluída nos próximos meses e deve contribuir para políticas públicas de fiscalização e educação sanitária no Vale do São Francisco.
Fonte: nossa voz










